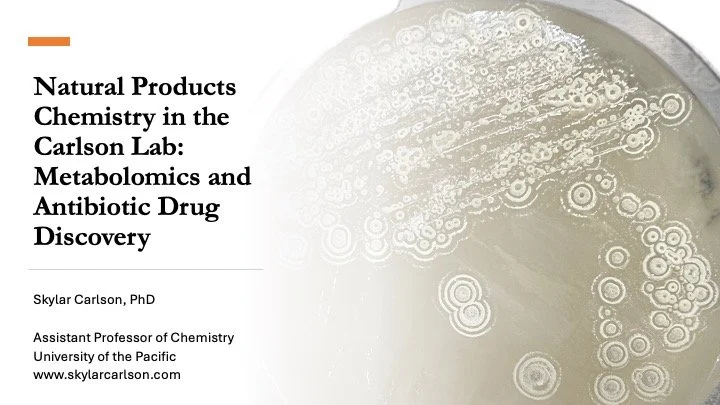

From Chicago to Carrie Bow Cay
I isolate and identify small molecules with biological activity and enjoy teaching others along the way. Marine adjacent analytical chemist.
About me
-
BS in Biochemistry Florida State University
PhD in Pharmacognosy from University of Illinois-Chicago
Postdoctoral appointments at University of Wisconsin-Madison and Smithsonian Marine Station
-
Check out the seminar I gave to my department in March 2024:
Checkout this short talk from Jan 2024 to a general audience at the library, “What’s my research?”
https://scholarlycommons.pacific.edu/orsp-pres/9/
My Experience
Cyanobacteria
Responsible for nitrogen fixation and photosynthesis, cyanobacteria produce a suite of bioactive small molecules (mostly peptides) that we are investigating for anticancer potential.
Curlew, Belize, August 2018
Photo credit: Abigail Engleman
Sponges
In pursuit of ESKAPE pathogen biofilm inhibitors we extracted small molecules from sponges collected in the Florida Keys.
Madison, Wisconsin 2016
Photo credit: @drbabyfish
Aquatic Sediments
Sampling aboard the RV Lake Gaurdian required a special kind of cold water personal protective equipment - gumby suits. We sampled the aerobic sediment from each of the Great Lakes for gram-positive actinomcyete bacteria.
Detroit, MI circa 2012
Photo credit: Brian T. Murphy (center, closed face flap)
All photographs copyright Skylar Carlson 2024 unless otherwise attributed.